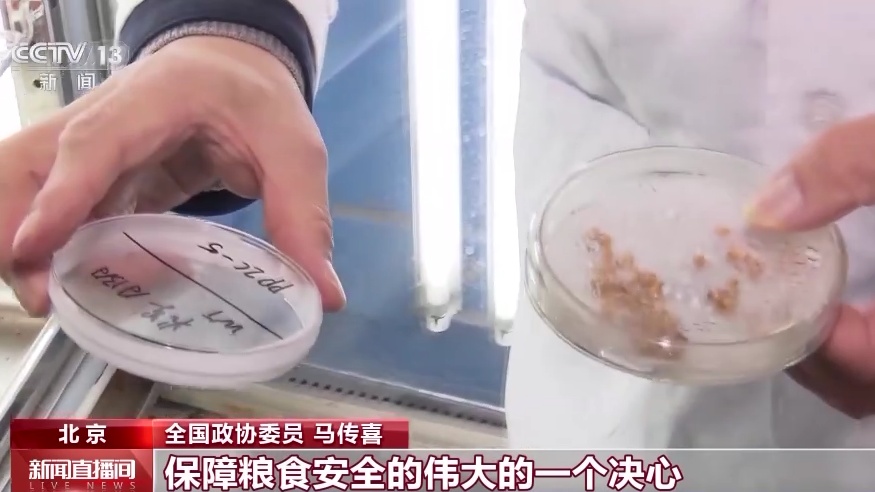

今年是全面贯彻落实党的二十大精神的开局之年,也是“十四五”规划承上启下的关键之年。新一届2100多名全国政协委员共聚北京,建言献策。今年两会,“中国式现代化”成为很多委员关注的热点,围绕中国式现代化,他们带来了什么样的建议和提案呢?
全国政协委员、安徽农业大学教授马传喜,今年两会他带来了最新培育的高产、多抗小麦种子。
全国政协委员 马传喜:我搞小麦育种,我们出的品种应该说最近5年里面是每年出一个国家级的品种,而且它的表现都相当优秀。这就是我们国家立足于科技自立自强,保障粮食安全的伟大的一个决心。
党的二十大报告擘画了中国式现代化的宏伟蓝图。今年两会,马传喜委员围绕如何加快构建中国特色农业产业体系,为中国式现代化的奋斗目标建言献策。

全国政协委员 马传喜:中国式的现代化首先是人口规模巨大的现代化,这么巨大的人口,重点是要保障粮食安全。所以我们必须建立我们的现代农业产业体系,运用先进的科技手段和装备来提高农业的生产效率,提高农民的生产的积极性,保证我们国民的粮食需求,保证经济的稳定发展。

环境资源界是本届全国政协的新增界别。85名委员来自环境资源领域的官员、学者、企业等各个领域。全国政协委员、宁夏农林科学院林业与草地生态研究所研究员蒋齐,30多年来扎根宁夏山区和沙区,从事荒漠化土地综合整治研究。这次两会,他围绕资源和环境协调发展带来多个提案,包括如何加快推动我国北方欠发达省区碳排放权改革,降碳、减污、扩绿,促进经济社会发展全面绿色转型。

全国政协委员 蒋齐:党的十八大以来,我们坚持绿水青山就是金山银山的理念,绿色、循环、低碳发展迈出了坚实步伐。在国家发展迈入高质量发展阶段,经济高质量发展要求人与自然和谐共生,这是中国式现代化的主要内容和鲜明特色。在全国政协这个平台上,我将在工作中发现问题,深入调研,多方听取意见,用心履职,和大家一起努力,让我们的天更蓝、地更绿、水更清,实现人与自然和谐共生的中国式现代化,实现中华民族伟大复兴。
全国政协委员、西安交通大学公共政策与管理学院教授杜海峰特别关注全面推进乡村振兴。

全国政协委员 杜海峰:乡村振兴战略它是接续脱贫攻坚战略,在微观上它就是要解决绝对贫困向相对贫困的治理。整个乡村振兴战略它的重心应该放在西部或者中西部,通过这个战略的实施去弥补城乡差距和地域差距。按照中国式现代化的发展的要求,也必须要把中西部农村的乡村振兴战略去推动好。
Copyright © 2001-2025 湖北荆楚网络科技股份有限公司 All Rights Reserved
互联网新闻信息许可证 4212025003 -
增值电信业务经营许可证 鄂B2-20231273 -
广播电视节目制作经营许可证(鄂)字第00011号
信息网络传播视听节目许可证 1706144 -
互联网出版许可证 (鄂)字3号 -
营业执照
鄂ICP备 13000573号-1
鄂公网安备 42010602000206号
版权为 荆楚网 www.cnhubei.com 所有 未经同意不得复制或镜像